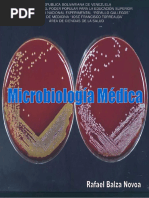

Microbiologia 1
Cargado por
Cristian MgkTemas abordados
- inmunidad activa,
- inmunología,
- técnicas de inmunofluorescenci…,
- micosis,
- antivirales,
- técnicas de ELISA,
- diagnóstico microbiológico,
- técnicas de radioinmunoanálisi…,
- materiales de microbiología,
- inmunidad pasiva
Microbiologia 1
Cargado por
Cristian MgkTemas abordados
- inmunidad activa,
- inmunología,
- técnicas de inmunofluorescenci…,
- micosis,
- antivirales,
- técnicas de ELISA,
- diagnóstico microbiológico,
- técnicas de radioinmunoanálisi…,
- materiales de microbiología,
- inmunidad pasiva
UNIVERSIDAD PRIVADA DEL VALLE
FACULTAD DE CIENCIAS DE LA SALUD
MICROBIOLOGIA I
GUIA PRACTICA DE LABORATORIO
COMPETENCIAS ESPECFICAS A SER EVALUADAS EN LA CLASE PRCTICA DE MICROBIOLOGIA I
SABER EVALUACIN DE PRCTICA Revisin y aplicacin de conocimiento previo (examen) previo) SABER HACER SER NOTA FINAL Nota Examen parcial parcial
ESTUDIANTES
Calidad de Desarrollo trabajo de la (mapas, prctica. casos (Uso Puntualidad clnicos, correcto resolucin de de Material) cuestionario)
Disciplina (Uso de vestimenta adecuada)
PUNTAJE
0 - 9
0-3
15
15
30
UNIVERSIDAD PRIVADA DEL VALLE SERVICIOS DE LABORATORIO LABORATORIO DE MICROBIOLOGIA Prctica No. 1
NORMAS BASICAS DE BIOSEGURIDAD EN EL LABORATORIO DE MICROBIOLOGIA
1. CONOCIMIENTO TEORICO REQUERIDO: Las medidas de seguridad en laboratorios son un conjunto de medidas preventivas destinadas a proteger la salud de los que all se desempean frentre a los riesgos propios derivados de la actividad, para evitar accidentes y contaminaciones tanto dentro de su mbito de trabajo, como hacia el exterios. En ese entendido la OMS se dio a la tarea de estudiar estos riesgos y clasificar a los laboratorios, para luego dar recomendaciones en lo que se refiere a normas de bioseguridad. Los laboratorios se clasifican en :
Nuestro laboratorio se encuentra en el grupo de riesgo 1, nivel bsico, en este nivel la OMS recomienda que es necesario para minimizar riesgos : El Smbolo internacional de peligro biolgico debe estar colocado en las puertas de los lugares donde se manipulen microorganismos que puedan resultar patgenos al humano. Slo se podr entrar a las zonas de trabajo personal autorizado. Las puertas del laboratorio deben mantenerse cerradas. No se autoriza la entrada de nios en las zonas de trabajo del laboratorio. Proteccin personal: Se usarn en todo momento batas o guardapolvos especiales para el trabajo de laboratorio. Se usarn guantes protectores apropiados para todos los procedimientos que pueden entraar contacto directo o accidental con sangre, lquidos corporales y otros materiales potencialmente infecciosos. Una vez utilizados los guantes, se retiraran de forma asptica y a continuacin se lavarn las manos. El personal y los estudiantes se lavaran las manos despus de manipular muestras y antes de salir del laboratorio. Se usarn lentes y caretas de seguridad para proteccin de los ojos y el rostro de salpicaduras, impactos y fuentes de radiacin ultravioleta artificial. Est prohibido usar las prendas protectoras fuera del laboratorio. Debe usarse calzado cerrado, prohibido entrar con sandalias. Est prohibido comer, fumar o beber en el laboratorio. 3
No debe almacenarse comida para consumo humano en el laboratorio. Procedimientos: Est estrictamente prohibido pipetear con la boca. No se colocar ningn material en la boca ni se pasar la lengua por las etiquetas. Todos los procedimientos tcnicos se practicarn de manera que se reduzca al mnimo la formacin de aerosoles . Todos los derrames, accidentes y exposiciones reales o potenciales a materiales infecciosos se comunicarn al supervisor del laboratorio. Se mantendr un registro escrito de estos accidentes e incidentes. Se elaborar y seguir un procedimiento escrito para la limpieza de todos los derrames. Los lquidos contaminados debern descontaminarse ( por medios qumicos o fsicos) antes de eliminarlos por el colector de saneamiento. Zonas de trabajo del laboratorio: El laboratorio se mantendr ordenado, limpio y libre de materiales no relacionados con el trabajo. Las superficies de trabajo se descontaminarn despus de todo derrame de material potencialmente peligroso y al final de cada jornada de trabajo. Todos los materiales, muestras y cultivos contaminados debern ser descontaminados antes de eliminarlos o de limpiarlos para volverlos a utilizar. Las ventanas que puedan abrirse estarn equipadas con rejillas que impidan el paso de artrpodos. Clasificacin de los residuos: Desechos generales o comunes son aquellos que no presentan un riesgo adicional para la salud humana y el ambiente y que no requieren de un manejo especial como papel, cartn, plsticos, restos de alimentos. Desechos peligrosos o especiales son aquellos que presentan un riesgo para la salud humana y el ambiente y que requieren de un manejo especial como sangre y hemoderivados, fluidos corporales, cultivos de agentes infecciosos, vacunas vencidas, cajas de petri, placas de frotis, rganos, tejidos, partes corporales. Desechos cortopunzantes agujas, hojas de bistur, hojas de afeitar, objetos de vidrio y cortopunzantes desechables. Desechos especiales frascos de antibiticos y sachett de medicamentos 2. COMPETENCIAS Identifica y aplica las normas bsicas de bioseguridad en laboratorio de microbiologa. Investiga la metodologas correcta para la eliminacin de los residuos generados en el laboratorio. Aplica la metodologa correcta para la eliminacin de los residuos generados en el laboratorio microbiologa. 4
3. MATERIALES Manual de Higiene y seguridad en Microbiologa. Normas de bioseguridad.
4. TIEMPO DE DURACION DE LA PRCTICA: Dos periodos de 50 minutos 5. METODOLOGIA Trabajo en grupos pequeos
6. CUESTIONARIO Y ACTIVIDADES 1. Realizar un mapa conceptual sobre normas de bioseguridad. 2. Esquematizar un mapa cognitivo en forma personalizado de manejo de residuos. 3. Clasifique los residuos. Residuos Jeringa con sangre Hojas de bistur Cajas petri cultivadas Papel de escritorio Tiras reactivas de orina Frasco con muestra Aguja hipodrmica Infeccioso Cortopunzante Comunes
UNIVERSIDAD PRIVADA DEL VALLE SERVICIOS DE LABORATORIO LABORATORIO DE MICROBIOLOGIA Prctica No. 2
MATERIALES E INSTRUMENTOS DE LABORATORIO EMPLEADOS EN MICROBIOLOGIA 1. CONOCIMIENTO TEORICO REQUERIDO El trabajo en un laboratorio de Microbiologa es significativamente diferente al de otros laboratorios, requiriendo de unos cuidados especiales ya que se debe trabajar en condiciones que se evite la contaminacin del operario, de las muestras y del ambiente. Por todo ello es necesario reconocer cada uno de los materiales que son utilizados en laboratorio de Microbiologa y reconocer el uso que se le da en el mismo. Es cierto que muchos materiales se comparten con otros laboratorios, sin embargo en microbiologa se le da un uso especial porque el objetivo es diferente. Ejemplo: el caso de un mechero, que se utiliza para esterilizar. 2. COMPETENCIAS Describe y dibuja el material empleado en las prcticas de microbiologa. Reconoce el uso correcto de la material y equipo en las prcticas de microbiologa. 3. MATERIALES, INSTRUMENTOS, REACTIVOS Y EQUIPOS Entre los materiales que se suelen emplearse con mayor frecuencia en el laboratorio de microbiologa se encuentran: Portaobjetos Cubreobjetos Tubos de ensayo Tubos de Hemlisis o Kant Cajas Petri Asas bacteriolgicas Matraces erlermeyer Pipetas Lavadores o Frascos lavadores Vidrios de reloj Gradillas Varillas de tincin Frascos goteros Probetas Embudos Morteros Bastones o Varillas de vidrio Esptula de Drigalski Pinzas de traspaso
Entre los instrumentos que se suelen encontrar en el laboratorio de microbiologa se encuentran: 6
Microscopios Centrifugas Autoclave Hornos de calor seco (Estufas) Incubadoras Baos de agua Cmara de anaerobiosis Refrigeradores y congeladores Campana flujo laminar Mecheros de alcohol y gas Balanzas
4. TIEMPO DE DURACION DE LA PRCTICA Dos periodos de 50 minutos. 5. METODOLOGIA Trabajo en grupos pequeos. Descripcin ordenada de cada uno de estos y realizar el correspondiente dibujo. Procedimientos de lavado, secado y proteccin de los mismos. Sealar los usos de cada uno de los materiales a utilizar en el laboratorio de Microbiologa. 6. CUESTIONARIO Y ACTIVIDADES 1.- Indique el uso y realice el dibujo que falta de instrumentos MATERIALES Portaobjetos USOS cada uno de los materiales e
DIBUJO
Cubreobjetos
Tubo de ensayo
Tubos de hemolisis
Caja petri
Pipetas graduadas
Vasos de precipitado
Vidrio de reloj
2.- Qu otros tipos de materiales e instrumentos de laboratorio utilizados en Microbiologa se pueden aadir a los ya enunciados? 3.- Esquematic un microscopio e identifique sus partes. 4.- Cite tipo de microscopios los mas empleados en el diagnostico microbiolgico. CURIOSIDADES Mesopotamia. Curiosa, que no llamativa, es la concepcin sobrenatural de la enfermedad. El mdico lo primero que deba hacer era diagnosticar al paciente identificando cul de los 6000 posibles demonios era el responsable del problema, con tcnicas adivinatorias como los vuelos de algunas aves, la posicin de los astros o los hgados de algunos animales. A la enfermedad se le denominaba Shrtu, palabra de origen asirio, que tambin poda identificarse como pecado, impureza moral, ira divina o castigo.
UNIVERSIDAD PRIVADA DEL VALLE SERVICIOS DE LABORATORIO LABORATORIO DE MICROBIOLOGIA Prctica No. 3
ESTERILIZACIN, DESINFECCIN, ASEPSIA Y ANTISEPSIA 1. CONOCIMIENTO TEORICO REQUERIDO:
Un aspecto importante en el control de las infecciones son los principios que rigen la limpieza, desinfeccin y esterilizacin. Evitar la transmisin de microorganismos potencialmente patgenos ya sea entre enfermos, del personal sanitario a los pacientes o a la inversa es una prioridad en todos los centros sanitarios. Por lo que es indispensable conocer estos conceptos para entender mas claramente en que momento usamos desinfectantes, antispticos o esterilizantes. ESTERILIZACIN: Es un proceso por el que se eliminan todas las formas de vida microbiana (Microorganismos patgenos y no patgenos), incluso las esporas bacterianas, se logra por medios fsicos y qumicos (Oxido de Etileno). DESINFECCIN: Es un proceso por el que se destruyen microorganismos patgenos, pero no siempre todos los microorganismos y esporas, se logra mediante mtodos qumicos sobre superficies u objeto inanimados( mobiliario, equipamiento, instrumental). ASEPSIA: significa ausencia o privacin de todos los grmenes patgenos o no. ANTISEPSIA : es la creacin de un medio disgenesico que obra por destruccin de los microorganismos o impidiendo su desarrollo. Lograr una buen asepsia y antisepsia es 9
fundamental para cualquier procedimiento bacteriolgico o quirrgico bsico como curaciones de heridas, quemaduras, suturas etc. Se debe hacer lo posible para evitar contaminacin microbiana que llegara a perjudicar al paciente as como el xito en la identificacin del microorganismo causante de infeccin. La antisepsia por su baja toxicidad se utiliza para la destruccin de microorganismos presentes en las superficie cutaneomucosa ( piel, heridas, mucosas, manos).
SUSTANCIAS QUIMICAS EMPLEADAS EN ASEPSIA Y ANTISEPSIA De acuerdo con las especificaciones de la FDA las sustancias que se utilizan como agentes anti-microbianos son: Alcoholes + glicerina: La mayora de las soluciones con base alcohlica utilizan isoprophanol, etanol, n-propanol o combinaciones de dos productos en concentraciones de 65 al 90%. Posee el tiempo de inicio accin ms rpido; no sirve para eliminar la suciedad. Clorhexidina: Preparaciones de gluconato de clorhexidina, en concentraciones del 0.5 al 1.0%. Posee un periodo de inicio accin intermedio y un efecto residual prolongado; Seis (6) horas. Se inhibe por surfactantes no inicos, aniones inorgnicos y orgnicos. Clorhoxylenol: Sustancia fenlica con un sustituto halgeno su eficacia es buena aunque su mayor fortaleza esta en su poca absorcin a travs de la piel. Su concentracin debe estar entre 0.3 y 3.75%. Yodo: Es reconocido como un excelentes antisptico pero puede genera irritacin de la piel. Las soluciones yodadas se presentan como una alternativa pero requieren una concentracin de 8% en jabones y del 10% en soluciones desinfectantes. Triclosn: Sustancia no inica que al ser integrada en jabones en concentracin de 0.2 al 2% acta como antimicrobiano. Alcoholes: Alcohol etlico y isopropilico, muestran una actividad antimicrobiana rpida de amplio espectro contra bacterias virus y hongos. Actividad optima cuando se diluyen con agua al concentraciones de 60 a 90%.
10
CATEGORIA DE MATERIALES De acuerdo al nivel de riesgo de infeccin, los materiales se clasifican en: Elementos crticos: Nivel de riesgo alto, son elementos que van a entrar en contacto con el torrente circulatorio o reas del cuerpo a travs de una ciruga. Deben ser estriles. Elementos Semicrticos: Tienen contacto con las mucosas sanas, pueden ser estriles o desinfectados en alto grado. Elementos No Crticos: Tiene contacto con la piel sana, debern ser descontaminados. LAVADO DE MANOS Lavado Higinico: Es el que se realiza diariamente de forma casera, disminuye la flora transitoria (flora que se adquiere por contacto con objetos contaminados). Se realiza con agua y jabn.
Lavado Antisptico: Elimina la flora transitoria y disminuye la flora residente (flora que habita normalmente en piel). Se emplea solucin jabonosa antisptica, cepillo y agua. Solo se cepillan las manos.
11
Lavado Quirrgico: Elimina la flora transitoria y disminuye la flora residente (flora que habita normalmente en piel). Se emplea solucin jabonosa antisptica, cepillo y agua. Se cepilla el antebrazo y el codo.
METODOS DE ESTERILIZACION
Incineracin
Flama directa (fuego) Aire caliente (estufa) Vapor de agua
Calor seco
Ebullicin
Calor hmedo Metodos fisicos Pasteurizacin
Tindalizacin
Rayos UV Radiaciones
Rayos Gamma
Filtracin
Mtodos qumicos
Oxido de etileno
12
CONTROLES DE ESTERILIZACION Estos controles son necesarios para cerciorarnos de la correcta esterilizacin del material: Controles Fsicos: Son los ms simples y menos precisos. Ej: Termmetro, Manmetro, Reloj. Controles Qumicos: Son ms precisos. Son cintas que cambian de color con la correcta esterilizacin. Controles Biolgicos: Son los ms exactos, pero lleva ms tiempo realizarlos. Son bolsas selladas que contienen microorganismos. Estas bolsas se colocan conjuntamente con el material a esterilizar, y luego de finalizado el proceso de esterilizacin se cultivan. FACTORES QUE INTERVIENEN EN LA DESINFECCION Los factores que intervienen en la desinfeccin son: La Temperatura El tipo de microorganismo La concentracin del Antisptico o Desinfectante La presencia de Materia Orgnica El Tiempo El pH La Naturaleza de la superficie a desinfectar
2. COMPETENCIAS Identifica las caractersticas de esterilizacin, desinfeccin, asepsia y antisepsia. Reconoce los mtodos de esterilizacin y su aplicacin dependiendo el caso. 13
Explica como intervienen los factores ambientales en la desinfeccin. Realiza asepsia de las manos por medio del lavado y cepillado usando tcnicas adecuadas. Realiza la esterilizacin del material bacteriolgico por flameado. Realiza la limpieza y preparacin de la piel o lugar en el cual se desee realizar una toma de muestra bacteriolgica o un procedimiento quirrgico bsico. 3. MATERIAL, REACTIVOS Autoclave de Chamberland Alcohol Mechero Bunsen Asas bacteriolgicas Pinzas Cajas Petri Papel madera o papel sbana Hilo de caa Pipetas Tubos de ensayo Algodn Matraz erlenmeyer Recipiente para el flameado Jabn desinfectante Cepillo de uas Hervidor de agua Pinza de traspaso Alcohol Alcohol yodado Autoclave
4. TIEMPO DE DURACION DE LA PRCTICA Dos periodos de 50 minutos. 5. METODOLOGIA Trabajo en grupos pequeos Flama directa Se realiza colocando un poco de alcohol en un recipiente junto con el material que debe ser de metal (pinzas, tijeras, bistures, espculos, etc.), Se enciende el alcohol y se deja el fuego hasta que se consuma, luego se deja enfriar el material para su utilizacin. Para esterilizar el asa bacteriolgica, se flamea con un mechero de alcohol o Bunsen, hasta que el filamento del asa tome color Rojo vivo. De atrs hacia delante. Aire caliente Esto se realiza en los Hornos Pasteur a temperaturas superior a los 180C por hora y media. Se pueden esterilizar pipetas, varillas de vidrio, esptulas de vidrio, material metlico como tijeras, pinzas, polvos termoestables, etc. 14
Calor hmedo Para esto se utiliza el autoclave. Se debe colocar agua en el fondo de la caldera. Acomodar el material en la cesta metlica. Adaptar la tapa y ajustar los tornillos para asegurar el cierre hermtico del autoclave. Verificar si el orificio de escape est abierto. Encender el autoclave y calentar hasta la salida de un chorro continuo de vapor de agua por la vlvula de escape, (para eliminar el aire residual). Cerrar la vlvula de escape. Cuando se alcance la Temperatura deseada por ejemplo 121C, regular la temperatura del autoclave, manteniendo la misma por 15 a 20 minutos. Concluida la esterilizacin, apagar el autoclave y dejar enfriar espontneamente. Esperar que la presin del manmetro marque 0. Abrir la vlvula de escape para asegurarse de que no hay presin en el autoclave. Abrir el autoclave y retirar el material esterilizado. Dispensar los medios de cultivo en el material de laboratorio. En autoclave se pueden esterilizar: material de vidrio, materiales metlicos, medios de cultivos, sustancias oleosas liquidas, pijamas mdicos, hisopos de algodn, etc. PRECAUCION No abrir nunca la vlvula de escape del autoclave antes de que enfre, porque la presin elevada podra proyectar la tapa y el agua caliente hasta el exterior, con riesgo para el operador, adems los lquidos podran entrar en ebullicin expulsando los tapones de algodn y mojarlos. Ebullicin Tomar un recipiente y llenar con agua, proceder a colocar el material que se desee esterilizar ejemplo: agujas y jeringas de vidrio, pinzas, mangos de bistur, etc. Dejar hervir el agua por 30 minutos. Posteriormente apagar y dejar enfriar. Pasteurizacin Este mtodo fue descubierto por Louis Pasteur en 1860 y se emplea para algunos lquidos termolbiles que no se pueden someter a temperaturas elevadas porque el calor desnaturaliza sus componentes. Este mtodo de utiliza para disminuir el nmero de microorganismos patgenos. La temperatura y el tiempo de pasteurizacin dependen del microorganismo patgeno ms resistente que se quiera destruir. Se emplea principalmente para lcteos, jugos y cerveza Tindalizacin Se conoce como la esterilizacin fraccionada y consiste en aplicar temperaturas correspondientes a 90C y 100C por un tiempo, luego incubar y al da siguiente otra vez el mismo proceso. Esto se realiza tres veces. Uso de radiaciones Se utiliza radiacin U.V y radiacin ionizante como por ejemplo: la gamma. La radiacin U.V puede ser letal sin embargo no atraviesa eficazmente el vidrio debido a esto se lo utiliza en pocas situaciones; como en lmparas que se puede colocar en una habitacin o
15
en una campana de seguridad biolgica. Se debe tener cuidado en el manejo de radiacin U.V. La radiacin gamma es excelente porque penetra profundamente los objetos, con esta radiacin se pueden esterilizar en fro antibitico, hormonas, suturas, jeringas de plstico. Filtracin Se emplea cuando la sustancia a esterilizar son alteradas en sus propiedades fsicas y qumicas si son sometidas a la accin del calor. Por ejemplo: Enzimas, Toxinas bacterianas, etc. Oxido de Etileno Es un gas reactivo, inflamable, incoloro, se combina con el agua dando etilenglicol (Producto toxico). Tiene gran poder de penetracin y no produce calor por lo que se pueden esterilizar materiales plsticos. Como es muy toxico luego de su ciclo de esterilizacin se debe dejar el material esterilizado airear en cmara por 8 horas antes de ser empleado. Lavado de manos Proceder al lavado de manos con agua y jabn antisptico y con cepillo de uas, refregarse en forma ordenada el dorso, la palma, los dedos, las uas as como el antebrazo. Se repite por 3 minutos. Enjuagar el jabn con abundante agua haciendo que esta escurra de las manos hacia los codos. Repetir tres veces. Enjuagar las manos con alcohol y dejar que se evapore. Esterilizacin del material Colocar en recipiente agua y agregar el material que se va esterilizar. El material como por ejemplo: jeringas, sondas, agujas y material de metal, debe ser esterilizados en un recipiente y se deja hervir. Una vez que lleg a la temperatura de ebullicin dejar el material 20 minutos y posteriormente se sacar el mismo con una pinza. Limpieza de la piel del paciente Lavar con agua y jabn Pincelar con alcohol, solucin yodada, mercurio-cromo, merthiolate. Se debe comenzar por el centro del lugar a limpiarse, para terminar en los bordes. La operacin deber repetirse dos veces. 6. CUESTIONARIO Y ACTIVIDADES 1. Cul mecanismo de accin del calor sobre los microorganismos? 2. De qu forma se esterilizaran mejor los siguientes materiales
16
MATERIAL Pipeta vidrio Caja petri de vidrio Medios de solido Guantes cultivo
MTODO DE ESTERILIZACIN
TIPO DE CALORTIEMPO
OTROS (ESPECIFIQUE)
Jeringas desechables Ropa quirrgica Pinzas quirrgicas tijeras Hojas de bistur Mango de bistur Asa bacteriolgica Sala de quirfano
3. Como intervienen cada uno de los factores implicados en la desinfeccin? 4. Desde su punto de vista cual es la importancia del lavado de manos. CURIOSIDADES Se llamaba Ignaz Phillipp Semmelweis. Haba nacido en Buda, la ciudad hngara ubicada a la derecha del Danubio, en 1818. A mediados del siglo, cuando era un joven mdico, inici su prctica obsttrica en el hospital general de Viena, Austria: el Allgemeines KrankenHaus. . "All, Semmelweis observaba con preocupacin que las parturientas atendidas por los estudiantes avanzados de medicina y mdicos recin recibidos tenan una tasa de mortalidad diez veces mayor que las asistidas por parteras y personal idneo, y siempre debido a la misma causa: una infeccin llamada fiebre puerperal o septis neonatal." . Cuando muri uno de sus profesores, el doctor Jacob Kolletschka, en 1847, Semmelweis descubri en la autopsia que haba demasiada similitud entre el corte de dedo sufrido por su maestro durante una autopsia y la fiebre puerperal que lo preocupaba. "Y as lleg a la conclusin de que la mayor mortalidad en la sala de parturientas atendida por los estudiantes avanzados de medicina y mdicos recin recibidos era causada porque hacan entrenamiento en todo el hospital, incluidas las autopsias, y transportaban grmenes cadavricos en sus manos. En cambio, las parteras y auxiliares tenan ya un cierto entrenamiento en partos y tomaban precauciones. Una de ellas era lavarse las manos.". Semmelweis prob su teora: los mdicos deban lavarse las manos cuidadosamente con agua clorada antes de ingresar en la sala de partos. Pese a la eficacia de la medida, pasaron muchos aos hasta que la comunidad mdica acept su hallazgo. . Semmelweis fue atacado, marginado y sus colegas lo tomaron por demente. Muri antes de los 50 aos, destruido ante la conjura de tantos necios, en el manicomio de Viena. .
17
18
UNIVERSIDAD PRIVADA DEL VALLE SERVICIOS DE LABORATORIO LABORATORIO DE MICROBIOLOGIA Prctica No. 4
TOMA DE MUESTRA 1. CONOCIMIENTO TEORICO REQUERIDO La actividad que desarrolla el laboratorio de microbiologa est orientada esencialmente al diagnstico microbiolgico de las enfermedades infecciosas. Una parte importante de esa actividad consiste en el aislamiento, la identificacin y la determinacin de la sensibilidad a los antimicrobianos de los microorganismos causales de estas enfermedades. Otra parte importante de la actividad de un laboratorio de microbiologa consiste en la deteccin de anticuerpos, antgenos y cidos nuclecos en diversas muestras (sangre, lquidos estriles, orina, etc.), tcnicas que resultan muy tiles en el diagnstico precoz de determinadas enfermedades infecciosas. La gran diversidad de muestras clnicas y de mtodos diagnsticos aplicables, son dos aspectos que diferencian el laboratorio de microbiologa de otros laboratorios clnicos. Por tanto es necesario tener un protocolo que permita la adecuada manipulacin de muestras que sern enviadas a otro laboratorio y los resultados obtenidos estarn, estrechamente relacionados con el xito del informe final. INDICACIONES PREVIAS A LA RECOLECCION DE MUESTRAS Si el paciente recolectara la muestra las instrucciones debern ser claras (Mejor si son por escrito). La muestra deber ser representativa del proceso infeccioso. La recoleccin deber realizarse antes de comenzar la terapia antimicrobiana o suspender el antibitico 48-72 horas antes de la toma de muestra. Cuando se realice cultivo y aislamiento de grmenes el material deber recolectarse en recipientes estriles. Una vez recolectada la muestra deber ser llevada al laboratorio lo ms rpido posible. Etiquetar correctamente las muestras. Toda muestra deber manejarse como si fuera potencialmente patgena. Cuando se realiza cultivo de material deber conocerse el lugar de donde proviene la muestra: Zonas corporales que normalmente son estriles (sangre, puncin de medula sea, liquido cefalorraqudeo, liquido sinovial, liquido pleural, liquido peritoneal, tracto respiratorio inferior, orina recolectada por puncin suprapbica), Zonas corporales que poseen flora normal comensal (boca, nariz, tracto respiratorio superior, piel, tracto genital, tracto gastrointestinal, orina recolectada por miccin media, sondas o bolsas recolectoras) Tabla 1.- Muestras clnicas recomendadas para el diagnstico microbiolgico de las infecciones ms comunes
19
Tipo de infeccin Bacteriemia Endocarditis Infeccin del catter Pericarditis Sistema nervioso central Meningitis Abscesos cerebrales Tracto respiratorio Faringoamigdalitis Sinusitis Otitis media Otitis externa Neumonia
Muestra Hemocultivos Hemocultivos/Vlvula/Verrugas Catter IV, piel conexin del catter pericatter,
Comentarios
Infecciones cardiovasculares y asociadas a dispositivos intravasculares (IV)
Lquido pericrdico LCR Aspirados de abscesos Exudado farngeo Aspirado sinusal Timpanocentesis Exudado odo externo Esputo, muestras obtenidas por fibrobroncoscopia, puncin transtorcica aspirativa, puncin transtraqueal, broncoaspirado Lquido pleural, abscesos Nasal aspirados de Diagnstico tosferina/Infecc. vricas Deteccin de S. aureus No vlidos los exudados nasales
Empiema y abscesos pulmonares
Nasofarngeo Infecciones oculares Conjuntivitis Queratitis Endoftalmitis Infecciones gastrointestinales Diarrea Infecciones intraabdominales Peritonitis Abscesos intraperitoneales y abscesos viscerales Colecistitis Tracto urinario Infeccin urinaria Orina (miccin media, sonda) Lquido peritoneal Aspirados de abscesos Lquido biliar Heces/Biopsia Aspirado duodenal intestinal/ Exudado conjuntival/raspado Raspado corneal Lquido intraocular
Orina obtenida mediante puncin Diagnstico de bacteriuria suprapbica anaerobios y de ITU en nios Tracto genital lceras genitales Ndulos genitales Uretritis Vulvovaginitis Raspado de la lcera Aspirado del ndulo Exudado uretral Exudado vaginal
por
Deteccin de S.agalactiae (tambin exudado rectal )
20
Tipo de infeccin Cervicitis Prostatitis Piel y tejidos blandos Imptigo, foliculitis, erisipela, celulitis, lceras, infecciones gangrenosas, abscesos cutneos, heridas y quemaduras Hueso y articulaciones Artritis Osteomielitis
Muestra Exudado endocervical Secrecin prosttica
Comentarios Acompaada de orina pre y post masaje prosttico
Preferiblemente aspirados tomados con jeringa y biopsias de tejido. Son menos recomendables las muestras tomadas con torundas Lquido sinovial Biopsia sea o exudado
4.- Sistemas de transporte para la investigacin de microorganismos aerobios
Sistema de transporte Torundas con medio de transporte Comentarios Torundas en tubos de plstico con medio de transporte que mantiene un pH favorable y previene la desecacin de la muestra. tiles para la investigacin de Chlamydia spp. y Bordetella spp. Pueden ser txicas para N. gonorrhoeae, U. urealyticum y virus. tiles para la toma de muestra de conexiones de catteres intravasculares. tiles para la investigacin de virus Pueden inhibir a Chlamydia spp. Cuando la torunda es de madera, puede inactivar a virus del grupo Herpes e interferir con las pruebas de identificacin de Ureaplasma. Torundas flexibles que emplean alambre en lugar de madera tiles para el transporte de orinas, esputos, broncoaspirados, lavados broncoalveolares, heces, biopsias. Lquidos estriles, catter telescopado, aspirados de abscesos y heridas Tubo estril con medio de transporte (Cary Blair) para enteropatgenos en heces. Tubo con fijador (alcohol polivinlico) para parsitos en heces. Tubo con conservante (cido bricoformiato de sodio) para orinas. Mantiene la poblacin bacteriana durante 48 h a temperatura ambiente sin necesidad de refrigeracin. tiles para pelos, escamas cutneas y uas
Torundas de alginato clcico
Torundas de dacrn Torundas de algodn
Torundas para exudados nasofarngeos Tubos estriles de boca ancha
Tubos estriles Tubos estriles con transporte o conservante medio de
Placas de Petri estriles
Tabla 5.- Sistemas de transporte para la investigacin de microorganismos anaerobios
Sistema de transporte Torundas con sistemas de transporte especficos para anaerobios Viales y tubos con atmsfera anaerobia Comentarios
Bolsas de anaerobiosis
Contienen un medio de transporte semislido con un agente reductor y un indicador. Cualquier coloracin azul de dicho medio indica exposicin al aire. La muestra se introduce en el interior de una bolsa impermeable en cuyo interior se introduce un catalizador y un generador de hidrgeno y CO2.
21
Jeringa para la obtencin de aspirados
Cuando no se dispone de ninguno de los sistemas anteriores o bien la cantidad de muestra es mnima, puede utilizarse la misma jeringa con la que se ha obtenido. Para ello hay que eliminar el aire y taponar la aguja con un tapn de goma.
2. COMPETENCIAS Emplea y describe mtodos y tcnicas para la obtencin adecuada de muestras para el diagnstico microbiolgico. Conoce los diferentes medios de transporte y tcnicas de envo de muestras al laboratorio microbiolgico. Realiza una solicitud correcta para el examen microbiolgico 3. MATERIALES, REACTIVOS Y EQUIPOS Bajalenguas Hisopos de algodn estriles Portaobjetos Mechero de alcohol Pinzas metlicas Colorantes de Gram Varillas de Tincin Guantes Jeringas y agujas Tubos de hemlisis Gradillas Anticoagulante Algodn Alcohol Ligaduras
4. TIEMPO DE DURACION DE LA PRCTICA Dos periodos de 50 minutos. 5. METODOLOGIA Trabajo en grupos pequeos
Muestra
Preparacin del paciente
Instrucciones especiales El recipiente donde se recolecta la muestra deber ser estril y no tocar la piel del paciente. En el caso de nios se podr emplear bolsa recolectora.
Orina chorro medio Mujeres: limpiar la previa higiene zona con agua y jabn, luego enjuagar con agua, colocar tampn vaginal, manteniendo separados los labios mayores y comenzar e evacuar en el inodoro; recoger el chorro medio despus de eliminar los
22
Muestra
Preparacin del paciente
Instrucciones especiales
primeros ml de orina. Varones: limpiar el glande con agua y jabn, luego enjuagar con agua; retraer la piel del glande; recoger el chorro medio despus de eliminar varios mL. Orina por Puncin Puncin en la vejiga, suprapbica previa asepsia de la regin con alcohol yodado Sangre venosa Limpiar el sitio de Extraer sangre durante puncin venosa con alcohol el episodio febril, extraer dos al 70 % o con alcohol muestras, de brazo izquierdo yodado. y derecho, no extraer ms de tres muestras en un periodo de 24 horas. Tracto genital Limpiar la piel antes Se puede aspirar el femenino de la recoleccin. lquido o se puede realizar un hisopado, o recolectar las secreciones con ayuda de un hisopo. Tracto genital Limpiar el glande con Recolectar las masculino agua y jabn. secreciones con hisopo o en tubo. Vas respiratorias Enjuagar con agua Pasar el hisopo por la superiores faringe antes de la recoleccin de faringe posterior y las la muestra amgdalas, con la ayuda de un baja lengua, sin tocar paladar, vula y dientes. Vas respiratorias La muestra El paciente debe inferiores recolectada es Esputo. obtenerlo por tos profunda. Enjuagar o hacer grgaras con agua antes de la recoleccin. Liquido Se realiza mediante cefalorraqudeo (LCR) puncin lumbar (PL) entre la 3 y 4 vertebra lumbar, previa asepsia de la zona con alcohol yodado 6. CUESTIONARIO Y ACTIVIDADES 1. En un paciente con onicomicosis. Cmo se toma la muestra? 2. En un paciente con sospecha de fiebre reumtica, que muestras requiere y que exmenes solicita y por que? 3. Cite 2 medios de transporte y explicar cuando los usara. 4. En que tipo de fluido no encontramos ningn microorganismo contaminante (Zonas normalmente estriles)? 23
5. En una zona normalmente estril cuantos microorganismos son necesarios encontrar para indicar infeccin. 6. Elabore una orden de laboratorio para extraccin de una muestra para un examen microbiolgico CURIOSIDADES Europa renacentista: G.Fracastoruis (1478-1553), mdico y poeta verones, llego a la conclusin de que las infeccones se deban a la transmisin de contagios por cuerpos diminutos que estan vivos y siempre producen la misma enfermedad, y califico a la sfilis como el mal francs. El nombre sfilis proviene del griego siph: cerdo y philus: amor. Recuerda al personaje de una obra, llamado Syphilo, que fue castigado por los dioses a sufrir una terrible enfermedad Por esta poca y durante mucho tiempo se utilizaron los mercuriales para el tratamiento de la sfilis. Este tratamiento mat ms enfermos que la propia sfilis, si a esto aadimos que en algunos hospitales, despus de la cura, le propinaban al enfermo una tunda de palos para castigar "la carne pecadora".
G.Fracastoruis (1478-1553),
Tratamiento de la sfilis en las tinas de sudacin utilizadas por Jean Fernel Se dice que el gngster (delincuente) americano Al Capone, el lder comunista Vladimir Lenin, el filsofo alemn Friedrich Nietzsche y el rey Enrique VIII de Inglaterra, entre otras personalidades famosas, tenan algo en comn: padecan de sfilis
24
UNIVERSIDAD PRIVADA DEL VALLE SERVICIOS DE LABORATORIO LABORATORIO DE MICROBIOLOGIA Prctica No. 5
TCNICAS INMUNOLGICAS 1. CONOCIMIENTO TEORICO REQUERIDO Una infeccin provoca respuesta inmunolgica dirigida contra uno o mas antgenos. En general se genera una respuesta humoral y celular y la medicin de una u otra puede ser la base para diagnosticar una infeccin. La inmunidad celular (Mediada por LiT), puede medirse o valorarse por hipersensibilidad drmica. La inmunidad Humoral (mediada por anticuerpos), en las infecciones intervienen principalmente dos inmunoglobulinas IgG (Infecciones crnicas) e Ig M (Infecciones agudas). El estudio de la inmunologa, es un rea amplia que cubre la investigacin y aplicacin clnica, se refiere a antgenos, anticuerpos y funciones de defensa del husped mediada por clulas, en especial en lo que se refiere a la inmunidad y enfermedad.
Una vez que el microorganismo ha ingresado y ha establecido el sitio primario de infeccin, se propagan de manera directa a travs de los tejidos o por medio del sistema linftico a la corriente sangunea. Esta infeccin puede ser transitoria o persistente. Ante esta situacin se genera una respuesta inmune de defensa, que segn el tipo de antgeno se producen anticuerpos de diferente especificidad. La reaccin de antgeno y anticuerpo da lugar al complejo antgeno-anticuerpo el cual es revelado por alguna tcnica inmunolgica. Es as que en una infeccin tambin se puede detectar el inmunocomplejo utilizando estas tcnicas que poseen una ventaja; el tiempo de realizacin es menor al de las tcnicas de cultivo tradicional. Es necesario remarcar que en otros casos es imprescindible el cultivo. USOS DE LAS TECNICAS INMUNOLOGICAS Diagnosticar infecciones Identificar microorganismos 25
Tipificar sangre para bancos de sangre Tipificar tejidos de trasplantes Cuantificar inmunoglobulinas, Hormonas, Marcadores tumorales
TECNICAS INMUNOLOGICAS Reaccin de Precipitacin: Se forma un inmunocomplejo que con el tiempo aumenta de tamao, volvindose insoluble en el medio dando lugar a un precipitado. Estas reacciones de precipitacin se pueden llevar a cabo en dos medios: Medios Lquidos: En donde el anticuerpo se encuentra en solucin. Ej: Reaccin de VDRL Medios Gelosados: Aqu el antgeno o anticuerpo esta en un soporte (agar-agar, agarosa, poliacrilamida). Ej: IDRS (inmunodifusin radial simple, que sirve para cuantificar IgM, IgD, IgG, IgA, IgAs Reaccin de Aglutinacin: Aqu el antgeno esta en forma de partcula. Puede ser: Aglutinacin directa: El antgeno particulado insoluble es aglutinado por el anticuerpo. Ej: Huddleson y Widal Aglutinacin Indirecta: Aqu se emplean transportadores a los que se adhiere en la superficie el antgeno particulado insoluble. Esos transportadores pueden ser: Partculas de Ltex: como ejemplo encontramos: Reaccin de Protena C reactiva, factor reumatoideo, Determinacin de Grupo sanguneo y factor, HCG, etc. Hemates: En este caso la tcnica recibe el nombre de Hemoaglutinacin, Ej: HA para Chagas, HA para Toxoplasmosis. Tambien podemos tener Inhibicin de la Hemoaglutinacin: Ej: AELO (Antiestreptolisina O) Hemoaglutinacin Reverso pasiva: Donde a los hemates se adhiere el anticuerpo. Ej: Hepatitis Reaccin de Inmunofluorescencia: Se basa en la fluorescencia que emiten determinadas sustancias y se observa en un microscopio especial de fluorescencia. Ej: TIF Toxoplasmosis (Test de inmunofluorescencia para Toxoplasmosis), TIF Chagas Reaccin de Radioinmunoanlisis: En esta reaccin el antgeno se marca con un radioisotopo. Ej: Hormonas, IgE, Marcadores tumorales, HIV, Hepatitis Reaccin de Enzimoinmunonalisis: Se emplea una enzima como marcador que acta sobre un sustrato que desarrolla color. Ej: Hormonas, IgE, Marcadores tumorales, HIV, Hepatitis
26
Pruebas cutneas: la hipersensibilidad drmica ofrece ciertas ventajas al determinar con facilidad y rapidez la respuesta inmunolgica (celular) del individuo a la exposicin previa a los agentes infecciosos. Ej: Virus de Herpes simple 2. COMPETENCIAS Identifica las pruebas serolgicas empleadas en el diagnstico microbiolgico . Realiza e interpreta la determinacin de grupo y factor sanguneo. Realiza e interpreta la determinacin de protena C reactiva. Analiza el fundamento de las pruebas serolgicas. Conoce otras pruebas empleadas en el diagnostico microbiolgico.
3. MATERIALES, REACTIVOS Y EQUIPOS Portaobjetos Guantes Jeringas y agujas Lancetas Gradillas Anticoagulante Algodn Alcohol Ligaduras Reactivo de PCR Reactivo de Grupo y Factor sanguneo Mondadientes 4. TIEMPO DE DURACION DE LA PRCTICA Dos periodos de 50 minutos 5.METODOLOGIA 27
Trabajo en grupos pequeos Determinacin de Grupo y Factor Determinacin de PCR latex Determinacin de Factor Reumatoideo Determinacin de la prueba de widal
6. CUESTIONARIO Y ACTIVIDADES: 1. Dibuje los tipos de ELISA, explique brevemente el fundamento y cual su utilidad para el diagnostico? 2. En qu consiste y la utilidad del inmunoblot o Western Blot. 3. Explique el fundamento de la Reaccin de polimerasa en cadena y sus aplicaciones. 4. Cite la diferencia entre las pruebas de PCR y PCR latex.
28
UNIVERSIDAD PRIVADA DEL VALLE SERVICIOS DE LABORATORIO LABORATORIO DE MICROBIOLOGIA Prctica No. 6
HIPERSENSIBILIDAD Las reacciones de hipersensibilidad pueden ser de diferentes tipos. Gell y Coombs, en 1963, las clasificaron en cuatro: hipersensibilidades tipo I, II, III y IV. La hipersensibilidad tipo I, o inmediata, es aquella que est mediada por anticuerpos tipo IgE. La tipo II, o citotxica, est mediada por anticuerpos citotxicos. La tipo III es una hipersensibilidad por inmunocomplejos. La tipo IV est mediada por clulas.
29
Alergia o Hipersensibilidad denota un estado en el cual una respuesta inmunitaria desencadena reacciones exageradas o inapropiadas que son nocivas para el husped. Son tpicas en un individuo dado, despus del primer contacto con un antgeno o alergeno. El primer contacto (que ocurre al principio de la vida del individuo) es un hecho preliminar necesario e induce a la sensibilizacin a ese alergeno (antgeno especifico) y es as como los siguientes contactos con dicho antgeno desencadenaran una respuesta hipersensible. Esta respuesta anmala, exagerada o inapropiada, da lugar a una reactividad de la que deriva lesin tisular u orgnica de grado variable. Como ya lo mencionamos se describen cuatro tipos de reacciones de Hipersensibilidad: Tipo I (Inmediata o Anafilactica), Tipo II (Por Citotoxica), Tipo III (Por Complejo Inmunitario) y Tipo IV (Retardada). La Hipersensibilidad Tipo I se manifiesta por reacciones tisulares a los minutos que el alergeno se combina con el anticuerpo compatible en las personas que previamente se han sensibilizado frente a el. Esta hipersensibilidad esta mediada principalmente por IgE. La unin de la IgE fijadas a las superficies de los mastocitos y el Alergeno desencadena la reaccin de hipersensibilidad, por la liberacin de mediadores vasoactivos (Histamina, Serotonina, Prostaglandinas, Tromboxanos, etc)( ver figuras)ejemplos choque anafilctico por inyeccin de frmacos y picaduras de insectos, cuadros de alergia como fiebre del heno y asma. La hipersensibilidad tipo II: son reacciones medidas por la interaccin de anticuerpos IgG e IgM preformados con antgenos presentes en la superficie celular y otros componentes tisulares. Activando al sistema del complemento, ejemplos reacciones transfusionales, miastenia gravis, eritroblastosis fetal, anemia hemoltica autoinmune, Sx de Goodpasture. La hipersensibilidad tipo III: son reacciones producidas por la existencia de inmunocomplejos (IgG) circulantes que al depositarse en los tejidos provocan activacin 30
de la fagocitosis y dao tisular por activacin del complemento, como sucede en lupus eritematoso sistmico, enfermedad del suero, reaccin de Arthur, artritis reumatoidea. La hipersensibilidad tipo IV son reacciones de hipersensibilidad celular o mediada por clulas, causadas por linfocitos T sensibilizados al entrar en contacto con el antgeno especifico, pudiendo producir una lesin inmunolgica por efecto txico directo o a travs de la liberacin de sustancias solubles como las linfocinas. Como en la prueba de la tuberculina o reaccin de Mantoux, dermatitis de contacto, rechazo de tejidos trasplantados, enfermedad de addison. 2. COMPETENCIAS Identifica los diferentes tipos de hipersensibilidad. Realiza la prueba de hipersensibilidad a la penicilina. Interpreta los resultados de la prueba. 3. MATERIALES, REACTIVOS Y EQUIPOS Penicilina sdica o potsica o ampicilina Jeringas Agujas de bisel corto #26 Mechero de alcohol Regla transparente calibrada en mm. Lpiz drmico Prednisona o Dexametasona
4. TIEMPO DE DURACION DE LA PRCTICA Dos periodos de 50 minutos 5. METODOLOGIA Trabajo en grupos pequeos Cargar en la jeringa de insulina 0.1 ml del preparado. Seleccionar el sitio de la inyeccin intradrmica (tercio externo y superior del antebrazo). Con el bisel arriba, introducir en la dermis, inyectar el antgeno, observando la formacin de un habn (no debe sangrar). Marcar con un lpiz drmico el sitio de la inyeccin. Observar, Interpretar e informar los resultados de la prueba. 6. CUESTIONARIO Y ACTIVIDADES 1. Compare y contraste las caractersticas de las cuatro tipos de hipersensibilidad y cite un ejemplos de cada uno de ellos. 2. Enumere tres mediadores liberados en la anafilaxia. 3. Indique la importancia de la Reaccin de Tuberculina. CURIOSIDADES 31
Sobre los vampiros En la porfiria, unos compuestos qumicos denominados porfirinas se acumulan en la piel, los huesos y los dientes. Algunas de estas porfirinas sufren una reaccin qumica por accin de la luz, lo que da lugar a nuevos compuestos que destruyen los tejidos cercanos y, como consecuencia, la piel se recubre de ampollas y los huesos se corroen. Esto, en fases avanzadas, puede llegar a provocar desagradables mutilaciones en las que orejas y nariz aparecen como corrodas, los labios deformados, las encas descarnadas, etc. En el proceso tambin se produce una fuerte anemia, lo que provoca una gran debilidad y una palidez casi cadavrica. En definitiva, esta enfermedad rene muchas de las caractersticas que se atribuyen a los vampiros, seres plidos que necesitan vivir en la oscuridad porque la luz solar les debilita y corroe hasta destruirlos, y que necesitan sangre fresca para reponer la suya. Adems, otra de las caractersticas tpicas de los vampiros, el horror a los ajos, tambin puede estar relacionada con esta enfermedad. Parece que los ajos contienen sustancias qumicas que pueden provocar que el efecto de la luz se haga ms intenso y se agrave la enfermedad. En definitiva, los vampiros no son personajes reales. Pero, si parece que algunas de sus caractersticas se han inspirado en una enfermedad muy humana: la porfiria. Que tipo de hipersensibilidad presentan????
32
UNIVERSIDAD PRIVADA DEL VALLE SERVICIOS DE LABORATORIO LABORATORIO DE MICROBIOLOGIA Prctica No. 7
INMUNIDAD ACTIVA ARTIFICIAL: VACUNAS CONOCIMENTO TEORICO REQUERIDO En el intento de encontrar proteccin real contra las enfermedades infecciosas que diezmaban pueblos enteros a hecho que el hombre con el tiempo des cubra un medio de proteccin. Los datos ms antiguos son del siglo VII, cuando budistas indios ingeran veneno de serpiente con el fin de ser inmune a sus efectos. El pueblo chino desde el siglo X practicaba la variolizacin con el fin de inocular el virus de la viruela de un enfermo a una persona susceptible. Las vacunas fueron descubiertas en 1771, por Edward Jenner, a partir de experimentos que realizaba con grmenes del a viruela que atacaba a la vaca, pero que a los trabajadores de las granjas hacia inmunes hacia esta enfermedad. De ah proviene su nombre, de la palabra latina vacca y este invento fue el inicio de todo un programa de inmunizaciones que ha permitido prevenir muchas enfermedades mortales o incapacitantes y evitar grandes epidemias. La inmunizacin o vacunacin es una forma de activar al sistema inmune, expone a las personas a una cantidad muy pequea y muy segura de algunos agentes infecciosos (microorganismos vivos atenuados o muertos o sus fracciones antignicas ) causantes de enfermedad. Esta exposicin ayuda al sistema inmune a reconocer y crear defensas contra esa enfermedad de forma eficiente. El individuo genera su propia respuesta inmune frente a un estmulo antignico. Debido al beneficio que causan las vacunas, existe a nivel mundial un programa ampliado de vacunacin (PAI) liderado por la OMS. En Bolivia el PAI funciona desde el ao 1979, en ese entonces la cobertura de menores de un ao no alcanzaba ni al 20%. Actualmente el incremento de la cobertura de vacunacin en muy bueno, alcanzando por ejemplo un 98% con la vacuna antisarampionosa y un 93% con la BCG. En 1994 se ha certificado la erradicacin de la poliomielitis en la Amrica, en Bolivia el ltimo caso registrado ocurri en 1987. El programa ampliado de inmunizaciones de segunda generacin, en Bolivia ,ha introducido nuevas vacunas en el esquema tradicional. Se reemplaz la vacuna DPT con la pentavalente y la antisarampionosa fue remplazada por la tripe viral que inmuniza contra sarampin, rubola y parotiditis. De acuerdo con la composicin qumica de las vacunas se clasifican de la siguiente forma:
33
Las contraindicaciones de la vacunacin:
34
35
2. COMPETENCIAS Explica los principios de la vacunacin. Conoce las caractersticas de los diferentes tipos de vacunas. Determina la importancia de la cadena de frio para el manejo de las vacunas. Comprende el esquema de inmunizacin del PAI y las No gratuitas.
3. MATERIALES Diapositivas Data display Auditrium
4. TIEMPO DE DURACION DE LA PRCTICA Dos periodos de 50 minutos 5. METODOLOGIA Trabajos en grupos pequeos 6. CUESTIONARIO Y ACTIVIDADES 1. Defina los siguientes conceptos: vacunas de grmenes vivos atenuados, grmenes muertos, toxoide, vacuna recombinante. 2. Cite las vas de administracin de las vacunas. 3. Cite ejemplos de vacunas con microorganismos atenuados, muertos o partes antignicas de los mismos. 4. Que entiende usted por la cadena de frio. 5. Cules son las vacunas que se deben aplicar a nios menores de un ao. 6. Cite vacunas contra virus y bacterias mas empleadas. 7. En un paciente de dos meses con infeccin de vas areas superiores y fiebre de 38C que vacunas aplicara. Justifique.
36
37
UNIVERSIDAD PRIVADA DEL VALLE SERVICIOS DE LABORATORIO LABORATORIO DE MICROBIOLOGIA Prctica No. 8
SEMINARIO: ANTIVIRALES 1. CONOCIMIENTO TEORICO REQUERIDO Dado que los virus comparten muchos de los procesos metablicos de la clula husped es difcil encontrar frmacos que sean selectivos para el patgeno. Sin embargo existen algunas enzimas que son especificas de los virus que son los posibles objetivos para el tratamiento medico. Los frmacos antivricos actualmente disponibles slo son eficaces mientras el virus se esta replicando. Los frmacos antivirales actan por los siguientes mecanismos:
: Ciclo viral Inhibicin de la penetracin en la clula husped Amantadina: acta sobre el virus influenza A. Inhibe la formacin de la cubierta ,su efecto principal es inhibir la decapsidacion viral o el desensamblaje del virion durante la endocitosis. Rimantadina: derivado 4-10 veces mas activa que la amantadina. Oseltamivir: inhibe la actividad de neuraminidasa del virus influenza. 38
Zanamivir:inhibe la actividad de neuraminidasa del virus influenza. Docosanol: interfiere en la fusion del VHS-1 y VHS-2 a las membranas de las celulas del huesped. Es de uso topico. La gammaglobulina: Neutraliza los virus Inhibidores de la DNA polimerasa: Aciclovir un derivado de la guanosina, inhibe selectivamente la ADN polimerasa vrica; eficaz contra herpesvirus; mnimos efectos indeseados. Ganciclovir, tambin un derivado de la guanosina, se fosforila y posteriormente se incorpora en el ADN vrico impidiendo su replicacin; utilizado en la infeccin por citomegalovirus (CMV), especialmente en pacientes con SIDA y retinitis por CMV; puede tener efectos indeseados graves. Vidarabina, un derivado de la adenosina, es un inhibidor relativamente selectivo de la ADN polimerasa vrica; eficaz contra herpes simple y varicela zoster; puede tener efectos indeseados graves. Tribavirin es similar a la guanosina y se cree que interfiere con la sntesis del ARNm vrico; puede inhibir a muchos virus ADN y ARN. Foscarnet inhibe la ADN polimerasa vrica fijndose al lugar de unin del pirofosfato; es bastante eficaz en la infeccin por CMV. Inhibidores de la transcriptasa inversa ITI: Zidovudina (AZT) , un anlogo de timina, es relativamente eficaz en VIH/ SIDA. Zalcitabina y didanosina proteasas. (DDI) se usan en combinacin con inhibidores de las
Inhibicin de los acontecimientos postraduccin. Los inhibidores de las proteasas (por ejemplo indinavir y saquinavir) inhiben la escisin de la protena inerte traducida en las protenas funcionales y estructurales. Se usan en combinacin con inhibidores de la transcriptasa inversa. Inmunomoduladores Los interferones, inducen en los ribosomas de las clulas del husped, enzimas que inhiben el ARNm vrico; se usan en la infeccin de la hepatitis B y pueden ser tiles en el SIDA. Interfern alfa: producen protenas efectoras en las clulas expuestas, lo que contribuye a un estado de resistencia viral. Imiquimod: modificador de la respuesta inmunitaria topica. 2. COMPETENCIAS Identifica los principales antivirales y sus usos mas frecuentes. Indica los principales mecanismos de accin de los antivirales. 3. MATERIAL Y EQUIPOS: Data display 4.TIEMPO DE DURACION DE LA PRCTICA
39
Dos periodos de 50 minutos 5. METODOLOGIA Seminario. 6. CUESTIONARIO Y ACTIVIDADES 1. Investigue cual es el tratamiento para un paciente portador de VIH? 2. Investigue cual es el tratamiento para un paciente con SIDA? 3. Complete el siguiente cuadro: Enfermedad Herpes virus 1 Citomegalovirus Influenza A Mononucleosis Infecciosa Dengue Hepatitis A Hepatitis B Fiebre amarilla Paludismo Varicela Tratamiento
40
UNIVERSIDAD PRIVADA DEL VALLE SERVICIOS DE LABORATORIO LABORATORIO DE MICROBIOLOGIA PRCTICA NO. 9
DIAGNOSTICO VIRAL 1. CONOCIMIENTO TEORICO REQUERIDO: Los mtodos utilizados para reconocer las infecciones por virus humanos pueden clasificarse en DIRECTOS e INDIRECTOS, segn persigan demostrar la presencia del virus o de alguno de sus constituyentes (antgeno o genoma viral) o bien la respuesta de anticuerpos especficos por parte del husped en el curso de la infeccin. Gran parte de las tcnicas utilizadas en el diagnstico clnico se basan en pruebas serolgicas que identifican anticuerpos especficos frente a diversas protenas antignicas. Sin embargo, existen circunstancias en las cuales son necesarias pruebas que detecten precozmente la infeccin viral (tratamientos especficos, medidas profilcticas, etc.). En algunas infecciones virales es posible detectar la presencia de antgenos virales previamente al desarrollo de la seroconversin, siendo esta prueba la nica evidencia de la exposicin al virus cuando no existe aumento de los niveles de anticuerpos circulantes (pacientes inmunodeprimidos). Igualmente la deteccin del genoma viral puede favorecer la precocidad del diagnstico viral y su confirmacin. En la ltima dcada se han desarrollado una serie de tcnicas para el diagnstico viral basadas en la deteccin de cidos nucleicos. De ellas la Reaccin en cadena de la polimerasa (PCR) es la ms utilizada. En el momento actual, la tendencia en el diagnstico virolgico consiste en emplear nuevas y ms sensibles tecnologas de deteccin de antgenos y de investigacin de cidos nucleicos con el propsito de lograr un diagnstico viral ms rpido. El desarrollo de quimioterapia antiviral efectiva es responsable de esta tendencia que hace de la identificacin rpida, sensible y especfica de los virus, una necesidad.
METODOS DIRECTOS Son aquellos que detectan: El virus como agente infeccioso (aislamiento viral). La presencia de antgenos virales (tcnicas inmunolgicas): Inmunofluorescencia (IF), Enzimoinmunoanlisis (EIA), Test de Aglutinacin. La presencia de cidos nucleicos virales (PCR, etc.). El virus como partcula viral (microscopa electrnica).
ROTAVIRUS Generalidades: Es un gnero de virus perteneciente a la familia Reoviridae. Se han identificado siete grupos, tres de los cuales (Grupo A, B y C) infectan a los humanos. El 41
grupo A es el ms comn, causando el 90% de las infecciones. Es la causa mas importante de gastroenteritis infantil en todo el mundo, Es responsable de aproximadamente el 50% de todos los casos de diarrea infantil que requieren hospitalizacin a causa de deshidratacin en Estados Unidos. En los pases subdesarrollados, los rotavirus pueden producir hasta un milln de fallecimientos al ao. La enfermedad est caracterizada por vmito y diarrea acuosa de 3 a 8 das, la diarrea es acuosa color amarillento con aspecto a yogurt. Suele remitir en un plazo de 12 a 60 horas sin complicaciones. Transmisin: Fecal-ora, periodo de incubacin de 24 a 48 hrs.
Diagnostico: Deteccin de anticuerpos por AGLUTINACI indirecta O ELISA en materia fecal y PCR-TI.
HIV El virus de inmunodeficiencia adquirida forma parte del gnero Lentivirus. Estos constituyen un grupo dentro de la familia Retroviridae. Desde su ingreso a la clula hospedadora, la cadena simple de cido ribonucleico (ARN) viral comienza su transformacin en una doble cadena de cido desoxirribonucleico (ADN) por accin de la enzima transcriptasa inversa que forma parte del virus. La integrasa y otros cofactores actan para que el ADN del virus se fusione con el ADN de la clula hospedadora a travs de la transcripcin en el genoma de la clula que aloja al virus. De esta manera, la clula queda infectada por el virus. Despus de este proceso, los lentivirus reaccionan de dos maneras posibles: puede ocurrir que el virus entre en latencia mientras la clula infectada contina en funciones, o bien, que el virus comience a replicarse activamente y libere viriones capaces de infectar otras clulas. Existen dos tipos del VIH, llamados VIH-1 y VIH-2. Transmisin: Transmisin sexual: relaciones sexuales sin condn con personas que viven con el VIH-SIDA. Transmisin a travs de sangre y productos de sangre contaminados con el virus, o herirse con instrumentos cortopunzantes infectados (va parenteral o sangunea). Este va incluye entre otras cosas transfusiones de sangre o productos de sangre, uso de agujas contaminadas y tatuajes. Transmisin vertical de una madre que vive con el VIH a su hijo a travs de la placenta durante el embarazo, durante el parto o en la lactancia a travs de la leche materna (va perinatal o materno-infantil).
No se transmite el VIH por: Compartir baos con otras personas o con personas que viven con el VIH-SIDA Compartir alimento y utensilios de cocina con otras personas o con personas que viven con el VIH-SIDA Picadura de insectos 42
Por compartir vida social Por compartir el ambiente del trabajo Abrazos, apretn de manos, besos Abrazar, besar o cuidar de una persona que vive con el VIH-SIDA
43
Diagnstico: Deteccin de anticuerpos por Elisa. Un resultado positivo debe ser corroborado con Westen blot o Reaccin de Polimerasa en cadena. El Elisa posee un periodo de ventana 44
de 3 meses (periodo en el cual el virus esta en el paciente y no puede ser detectado en el laboratorio) por ello ante un accidente con un elemento cortante o relacin sexual insegura se deber corroborar un nuevo test a los 3 meses. HEPATITIS A, B y C Las Hepatitis virales son enfermedades generalizadas que afectan primariamente al hgado. Estos virus producen una inflamacin aguda del hgado que trae como consecuencia una enfermedad clnica caracterizada por fiebre, sntomas gastrointestinales tales como nauseas y vmitos e ictericia. Independientemente del tipo de virus, durante la enfermedad aguda se observan lesiones histopatolgicas idnticas. HEPATITIS A (HAV) de 15-45 das HEPATITIS B (HBV) 50-180 das 15-29 aos Hepadnaviridae, Virus de ADN Parenteral, sexual, Trasplacentaria, Leche materna, Saliva Si HEPATITIS C (HCV) 14-120 das Adultos Flaviviridae, de ARN Virus
Periodo Incubacin Edad
Nios y adultos jvenes Familia a la que Picornaviridae, pertenece Heparnavirus, Virus de ARN Va de Transmisin Fecal-oral
Parenteral, sexual, Trasplacentaria, Leche materna, No
Existencia Vacuna Diagnostico serolgico
de Si
Determinacin de Determinacin de Determinacin de IgG e IgM para HVA HBsAg, HBcAg, IgG e IgM para HVC por ELISA HBeAg, IgG e IgM por ELISA HBc, Anti HBs, Anti HBe por ELISA
2. COMPETENCIAS Identifica los mtodos de diagnostico para las enfermedades virales. Diferencia las caractersticas clnicas bsicas de algunas enfermedades virales. Elige adecuadamente el mtodo diagnsticos correspondiente para cada enfermedad viral. . 3. MATERIALES Data display. 4. TIEMPO DE DURACION DE LA PRCTICA Dos periodos de 50 minutos 5. METODOLOGIA Trabajo en grupos pequeos con socializacin.
45
6. CUESTIONARIO Y ACTIVIDADES Resuelva los siguientes cuadros clnicos: 1. En el caso de sospechar que un neonato est infectado, el mismo proviene de una mujer seropositiva para HIV. Referente al diagnstico Qu tipo de acciones deberamos tomar y por qu? 2. Cite y explique en que consisten las pruebas de presuncin y de confirmacin para el diagnostico del VIH.
3. Se dosaron los siguientes antigenos y anticuerpos para hepatitis e interprete el cuadro:
HBsAg + + + -
Anti HBs +/++
Anti HBc (IgG) + +++ +/+++ -
Anti HBc (IgM) + +/-
HBeAg + + -
Anti Hbe +
4. Interprete el siguiente cuadro:
46
UNIVERSIDAD PRIVADA DEL VALLE SERVICIOS DE LABORATORIO LABORATORIO DE MICROBIOLOGIA Prctica No. 10
SEMINARIO: MICOSIS 1. CONOCIMIENTO TEORICO REQUERIDO Las infecciones fngicas se denominan micosis y en general pueden dividirse en: infecciones superficiales (que afectan piel, uas, cuero cabelludo o membranas mucosas) y sistmicas (que afectan tejidos mas profundos y rganos). Muchos de los hongos que pueden producir micosis viven en asociaciones con humanos como comensales, o estn presentes en el ambiente; pero, hasta tiempos recientes, las infecciones superficiales graves eran relativamente raras y las sistmicas eran muy raras (al menos en zonas relativamente climticas fras y templadas). En estas zonas una infeccin fngica normalmente consiste en un pie de atleta o candidiasis oral o vaginal que producen molestias, pero apenas significan un riesgo para la vida. Sin embargo, en los ltimos 30 aos ha habido un constante aumento en la incidencia de infecciones fngicas sistmicas secundarias graves. Uno de los motivos es la utilizacin generalizada de antibiticos de amplio espectro que eliminan o merman poblaciones bacterianas no patgenas que normalmente compiten con los hongos. Otro es el aumento en el nmero de pacientes con una respuesta inmune reducida debido al SIDA o a la accin de frmacos inmunodepresores o antineoplsicos; esto ha conllevado un aumento del predominio de infecciones oportunistas, es decir infecciones por hongos que normalmente son inocuos o que se eliminan rpidamente en personas inmunocompetentes. Clasificacin de las micosis: Micosis sistmicas. Candidiasis sistmica oportunista Meningitis Endocarditis criptocosica Aspergilosis pulmonar oportunista Mucormicosis rinocerebral Blatomicosis Histoplasmosis Coccidiomicosis Paracoccidiomicosis Micosis superficiales pueden clasificarse en: Dermatomicosis ( piel, pelo, uas causados por dermatofitos) los mas comunes tias Candidiasis superficial (boca, vagina o piel)
47
Mecanismos de accin de los antimicticos Antifngico Flucitosina Ketoconazol, clotrimazol Fluconazol Anfotericina B Nistatina Terbinafina Itraconazol Mecanismos de accin Inhibicin sntesis de DNA y RNA Inhibe enzimas lanosterol 1,4 alfa desmetilasa dependiente de citocromo p-450 Enzimas lanosterol Unen al ergosterol y dao oxidativo de la membrana Unen al ergosterol y dao oxidativo de la membrana Inhibicin del esculeno Enzimas lanosterol Va Oral Oral, tpica
bifonazol,
Oral, IV IV, tpica Oral, tpica Oral, tpica, Oral. IV
Indicaciones de los antifngicos: Enfermedad Infeccin sistmica Candidiasis sistmica Criptococosis (meningitis) Aspergilosis sistmica Blastomicosis Histoplasmosis Coccidiomicosis Paracoccidiomicosis Mucormicosis Esporotricosis diseminada Infecciones superficiales Dermatomicosis Pie de atleta Tia cutnea Tinea capitis Onicomicosis Candidiasis Piel Boca Vagina Candidiasis mucocutnea crnica Frmacos Anfotericina; flucitosina, fluconazol Anfotericina; itraconazol Anfotericina; itraconazol Anfotericina; itraconazol Anfotericina; itraconazol; fluconazol Anfotericina; itraconazol; fluconazol Anfotericina; itraconazol; fluconazol Anfotericina; flucitosina Anfotericina; itraconazol
Un azol tpico o itraconazol oral Un azol tpico o itraconazol oral; terbinafina oral Itraconazol oral Terbinafina oral, amorolfina tpica. Un azol tpico, nistatina tpica Un azol o nistatina tpica, fluconazol oral. Un azol tpico, fluconazol oral. Fluconazol, ketoconazol.
2. COMPETENCIAS Comprender las principales infecciones fngicas. 48
Identifica los frmacos antifngicos en las principales infecciones fngicas.
3. MATERIALES Laminas teidas Aceite de inmersin Microscpios
4.TIEMPO DE DURACION DE LA PRCTICA Dos periodos de 50 minutos. 5. METODOLOGIA Trabajo en grupos pequeos . Observacin en microscopio de las lminas teidas. 6. CUESTIONARIO Y ACTIVIDADES 1- Indicar los principales mecanismos de accin de: Frmaco Azoles Nistatina Terbinafina Flucitosina Anfotericina Mecanismo de accin
2.-
Cite el tratamiento incluya medicamento, via de administracin , tiempo de tratamiento y complicaciones, de las siguientes micosis: Patologa Medicamento Va de administracin Tiempo de tratamiento Complicaciones
Pie de atleta Pitiariaisis Tia corporis Rubeola
49
Tia capis Histoplasmosis Onicomicosis Esporotricosis Criptococosis Mucormicosis Candidiasis oral Carbunco
50
También podría gustarte
- Control Microbiológico de Superficies AlimentariasAún no hay calificacionesControl Microbiológico de Superficies Alimentarias5 páginas
- Cuestionarios de Biblia y CulturaAún no hay calificacionesCuestionarios de Biblia y Cultura19 páginas
- Microbiologia Medica-1 BALZA PDFAún no hay calificacionesMicrobiologia Medica-1 BALZA PDF177 páginas
- Disfunción Endotelial: Conceptos y Efectos100% (1)Disfunción Endotelial: Conceptos y Efectos68 páginas
- Actividades sobre Células ProcariotasAún no hay calificacionesActividades sobre Células Procariotas19 páginas
- Línea del tiempo y clasificación microbianaAún no hay calificacionesLínea del tiempo y clasificación microbiana4 páginas
- Dinosaurios: Tipos y Nombres AcuáticosAún no hay calificacionesDinosaurios: Tipos y Nombres Acuáticos7 páginas
- Introduccion A La Microbiologia y Parasitologia - Gutierrez Monroy Lizbeth-302Aún no hay calificacionesIntroduccion A La Microbiologia y Parasitologia - Gutierrez Monroy Lizbeth-3022 páginas
- Características de Bacterias PatógenasAún no hay calificacionesCaracterísticas de Bacterias Patógenas39 páginas
- Historia y avances en microbiologíaAún no hay calificacionesHistoria y avances en microbiología45 páginas
- Atlas de Medios de Cultivo BacterianoAún no hay calificacionesAtlas de Medios de Cultivo Bacteriano27 páginas
- Diagnóstico Serológico de Salmonella y BrucellaAún no hay calificacionesDiagnóstico Serológico de Salmonella y Brucella3 páginas
- Análisis de Datos y Procesamiento de Información100% (2)Análisis de Datos y Procesamiento de Información12 páginas
- Características y funciones de la sangreAún no hay calificacionesCaracterísticas y funciones de la sangre46 páginas
- Características de EnterobacteriasAún no hay calificacionesCaracterísticas de Enterobacterias15 páginas
- Manual de Practicas de BacteriologiaAún no hay calificacionesManual de Practicas de Bacteriologia25 páginas
- Inmunidad en Mucosas: Funciones y MecanismosAún no hay calificacionesInmunidad en Mucosas: Funciones y Mecanismos7 páginas
- Extracción y Análisis de Sangre ClínicaAún no hay calificacionesExtracción y Análisis de Sangre Clínica45 páginas
- Descubrimientos de Pasteur y KochAún no hay calificacionesDescubrimientos de Pasteur y Koch2 páginas
- Microbiología de Streptococcus en SaludAún no hay calificacionesMicrobiología de Streptococcus en Salud6 páginas
- Estructura y función de los ribosomasAún no hay calificacionesEstructura y función de los ribosomas2 páginas
- Tratamiento de Migrañas: MigraDorixinaAún no hay calificacionesTratamiento de Migrañas: MigraDorixina2 páginas
- Tipos y Efectos de la Acción FarmacológicaAún no hay calificacionesTipos y Efectos de la Acción Farmacológica1892 páginas
- Métodos de Identificación BacterianaAún no hay calificacionesMétodos de Identificación Bacteriana31 páginas
- Introducción a la Microbiología y Bacteriología100% (1)Introducción a la Microbiología y Bacteriología177 páginas
- Actinomycetos y Microbiología 2017Aún no hay calificacionesActinomycetos y Microbiología 20172 páginas
- Historia y Desarrollo de la Microbiología100% (1)Historia y Desarrollo de la Microbiología17 páginas
- Inmunidad Mucosal: Respuesta y ToleranciaAún no hay calificacionesInmunidad Mucosal: Respuesta y Tolerancia8 páginas
- Introducción a la Micología MédicaAún no hay calificacionesIntroducción a la Micología Médica44 páginas
- Características y Patogenicidad de EnterobacterAún no hay calificacionesCaracterísticas y Patogenicidad de Enterobacter24 páginas
- Bioseguridad y Materiales en MicrobiologíaAún no hay calificacionesBioseguridad y Materiales en Microbiología64 páginas
- Bioseguridad en Laboratorio de MicrobiologíaAún no hay calificacionesBioseguridad en Laboratorio de Microbiología64 páginas
- Bioseguridad en Laboratorios de MicrobiologíaAún no hay calificacionesBioseguridad en Laboratorios de Microbiología210 páginas
- Re-10-Lab-034 Microbiologia I (Med) v4Aún no hay calificacionesRe-10-Lab-034 Microbiologia I (Med) v459 páginas
- Bioseguridad en Laboratorio de MicrobiologíaAún no hay calificacionesBioseguridad en Laboratorio de Microbiología49 páginas
- Seguridad y Materiales en MicrobiologíaAún no hay calificacionesSeguridad y Materiales en Microbiología10 páginas
- Bioseguridad en Laboratorio de Microbiología100% (1)Bioseguridad en Laboratorio de Microbiología21 páginas
- Bioseguridad en Laboratorios de MicrobiologíaAún no hay calificacionesBioseguridad en Laboratorios de Microbiología45 páginas
- Normas y Seguridad en MicrobiologíaAún no hay calificacionesNormas y Seguridad en Microbiología18 páginas
- Desinfección Concomitante en SaludAún no hay calificacionesDesinfección Concomitante en Salud13 páginas
- Método Ball para Evaluar EsterilizaciónAún no hay calificacionesMétodo Ball para Evaluar Esterilización18 páginas
- GCF FO 315 018 Lista de Chequeo Esterilizacion100% (1)GCF FO 315 018 Lista de Chequeo Esterilizacion6 páginas
- G03 R00 Guia para La Aplicacion de Condiciones Ambientales en Labs ClinicosAún no hay calificacionesG03 R00 Guia para La Aplicacion de Condiciones Ambientales en Labs Clinicos7 páginas
- Protocolo de Prácticas en MicrobiologíaAún no hay calificacionesProtocolo de Prácticas en Microbiología141 páginas
- Practica Esterilizacion de Materiales y Preparacion de Medios de CultivoAún no hay calificacionesPractica Esterilizacion de Materiales y Preparacion de Medios de Cultivo4 páginas
- Técnicas Microbiológicas y SiembrasAún no hay calificacionesTécnicas Microbiológicas y Siembras22 páginas
- Métodos de Esterilización: Guía CompletaAún no hay calificacionesMétodos de Esterilización: Guía Completa6 páginas
- Guía de Procedimiento para La Elaboración de Torundas100% (2)Guía de Procedimiento para La Elaboración de Torundas2 páginas
- Cuestionario Autoclaves 11-08-23 - Pauta Corrección100% (3)Cuestionario Autoclaves 11-08-23 - Pauta Corrección11 páginas
- Requerimientos para Autoclave SBMAún no hay calificacionesRequerimientos para Autoclave SBM9 páginas
- Manual Limpieza Desinfeccion Esterilizacion General Instrumentos R WolfAún no hay calificacionesManual Limpieza Desinfeccion Esterilizacion General Instrumentos R Wolf79 páginas
- Enfermería Perioperatoria: Cuidados y ProcesoAún no hay calificacionesEnfermería Perioperatoria: Cuidados y Proceso11 páginas
- Esterilización de Cristalería: Métodos y VentajasAún no hay calificacionesEsterilización de Cristalería: Métodos y Ventajas3 páginas
- Normas Generales de Seguridad en Laboratorios100% (2)Normas Generales de Seguridad en Laboratorios28 páginas
- Protocolo de Esterilizacion A VaporAún no hay calificacionesProtocolo de Esterilizacion A Vapor5 páginas
- Programa de Trabajo de Ceye 2012-2015 ISSSTE92% (65)Programa de Trabajo de Ceye 2012-2015 ISSSTE76 páginas
- Métodos de Esterilización en SaludAún no hay calificacionesMétodos de Esterilización en Salud7 páginas
- NOM-152-SSA1-1996, Que Establece Las Especificaciones SanitAún no hay calificacionesNOM-152-SSA1-1996, Que Establece Las Especificaciones Sanit16 páginas
- Control de Medios de Cultivo en MicrobiologíaAún no hay calificacionesControl de Medios de Cultivo en Microbiología16 páginas